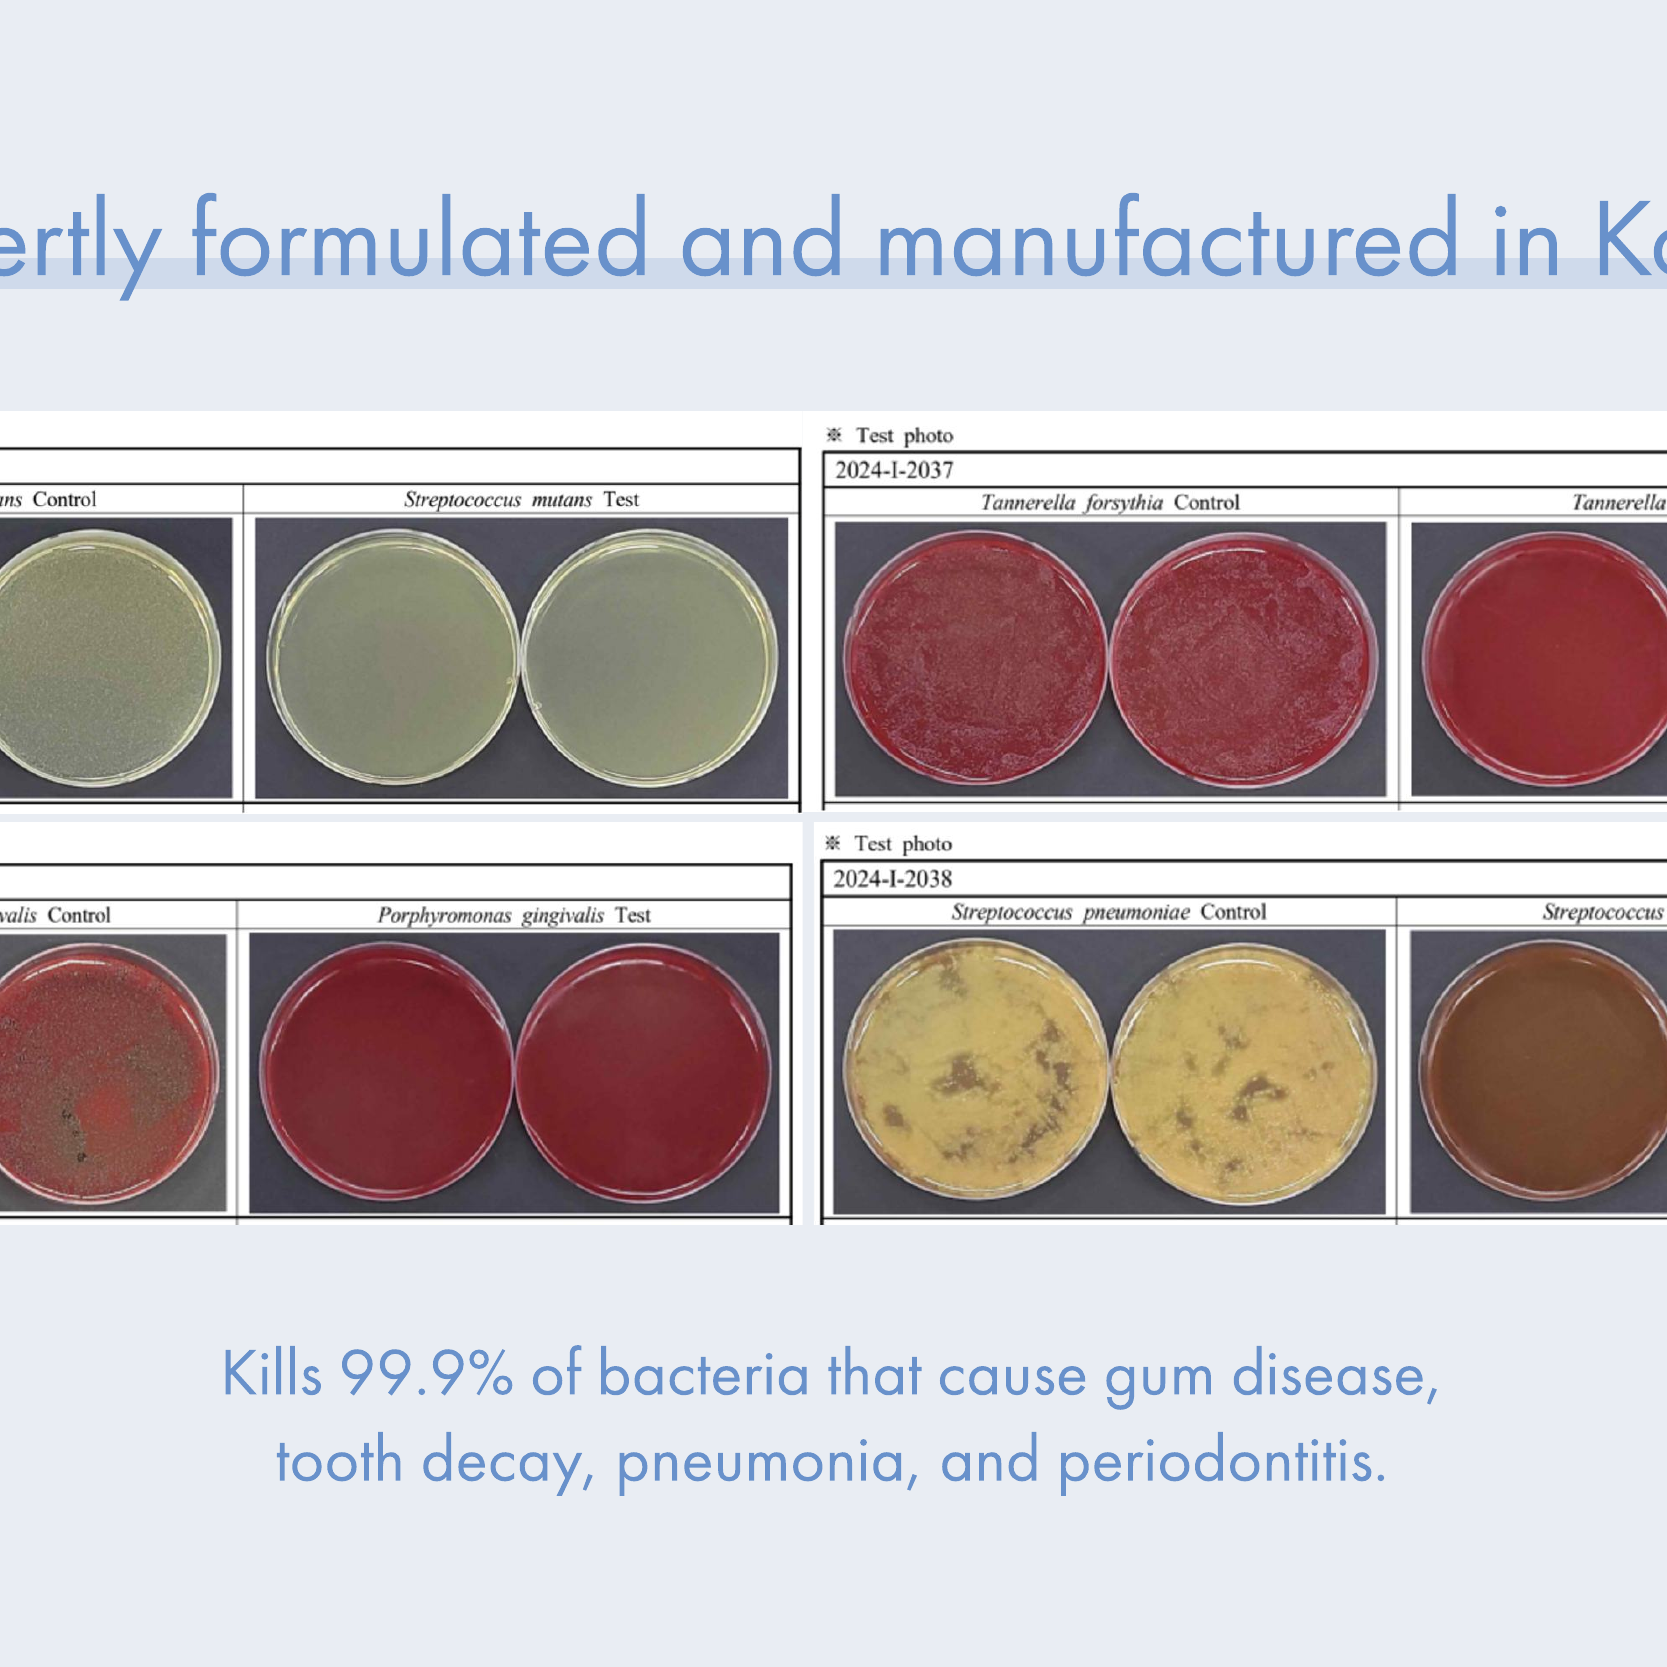

Still haven’t worn the spooky jacket, but Jeje’s Korean fashion style never fails to bring out the best look.
Haven't worn it yet, too cold in New Zealand
Well cut and looks expensive, yet classic and slimming.
Love the soft linen texture, falls nicely on your body.
Only wore three times the front side is starting to fray here and there.
Love the trousers - its so comfortable! The checkered fabric looks great too.- Easy to pair and so versatile!
This is hands-down my favourite tee. Nice cutting and comfortable material.
Love the texture!
Material looks old after one wash
Love it! Comfortable, good length, falls well, good cut, fits my height of being short waisted and petite.
I wear it for work under a casual jacket and it is superb!
Plain and simple; easy to wear.
I like the material very much, thick but comfortable and not hot. And I like the design n cut just right for my height 😁
These shorts are fantastic! They’re lightweight, breathable, and perfect for everyday wear.
“Great hoodie! The zip-up design is super convenient, and the fabric is soft and cozy. Perfect for layering and feels durable. Fits true to size. Highly recommend!”
“Love this linen dress! It’s lightweight, breathable, and perfect for summer. The fit is stylish and comfy, and the quality is great. It wrinkles easily, but that’s part of its charm. Highly recommend!”
Good cut, simple n smart-looking shorts suitable to pair with any tops!
Comfortable and cute shirt.
A colorful shop with products for the young to the senior. Great place to shop!
Its Christmas, A Time To show our Love, Happy Shopping
Thank you, Pollyanna for taking the time to leave such a great review! We truly appreciate your loyalty and support. It motivates us to keep providing the best products and service. 😊
Item Well received , same as the photo shown .
Thank you so much for your review! We’re thrilled to hear you’re happy with your purchase. Your support means the world to us. We look forward to serving you again